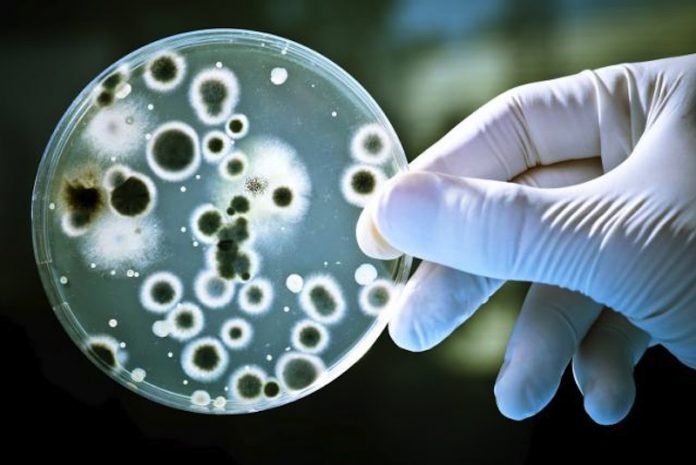
Bacterias podrían ayudar a limpiar contaminación por antibióticos

Bacterias podrían ayudar a limpiar contaminación por antibióticos
[Investigadores estadounidenses descubrieron que algunas bacterias convierten los medicamentos en alimentos, lo que podría conducir a nuevas formas de limpiar el suelo y los cursos de agua contaminados con antibióticos.
Los investigadores de la Facultad de Medicina de la Universidad de Washington en San Luis estudiaron cómo algunas bacterias pueden desarmar los antibióticos atándolos, otros pueden bombearlos antes de que puedan funcionar y algunos pueden comerlos.
Explicó que entender cómo las bacterias hacen esto puede ayudar en el diseño de nuevos y mejores antibióticos, además de resolver algunos de los problemas que provocan la resistencia a los antibióticos.
Las prácticas industriales y agrícolas modernas están acelerando el aumento de la resistencia a los antibióticos mediante la saturación del medio ambiente con medicamentos activos.(Agencias)]
Los investigadores de la Facultad de Medicina de la Universidad de Washington en San Luis estudiaron cómo algunas bacterias pueden desarmar los antibióticos atándolos, otros pueden bombearlos antes de que puedan funcionar y algunos pueden comerlos.
Explicó que entender cómo las bacterias hacen esto puede ayudar en el diseño de nuevos y mejores antibióticos, además de resolver algunos de los problemas que provocan la resistencia a los antibióticos.
Las prácticas industriales y agrícolas modernas están acelerando el aumento de la resistencia a los antibióticos mediante la saturación del medio ambiente con medicamentos activos.(Agencias)]
Share










En… Redes Sociales